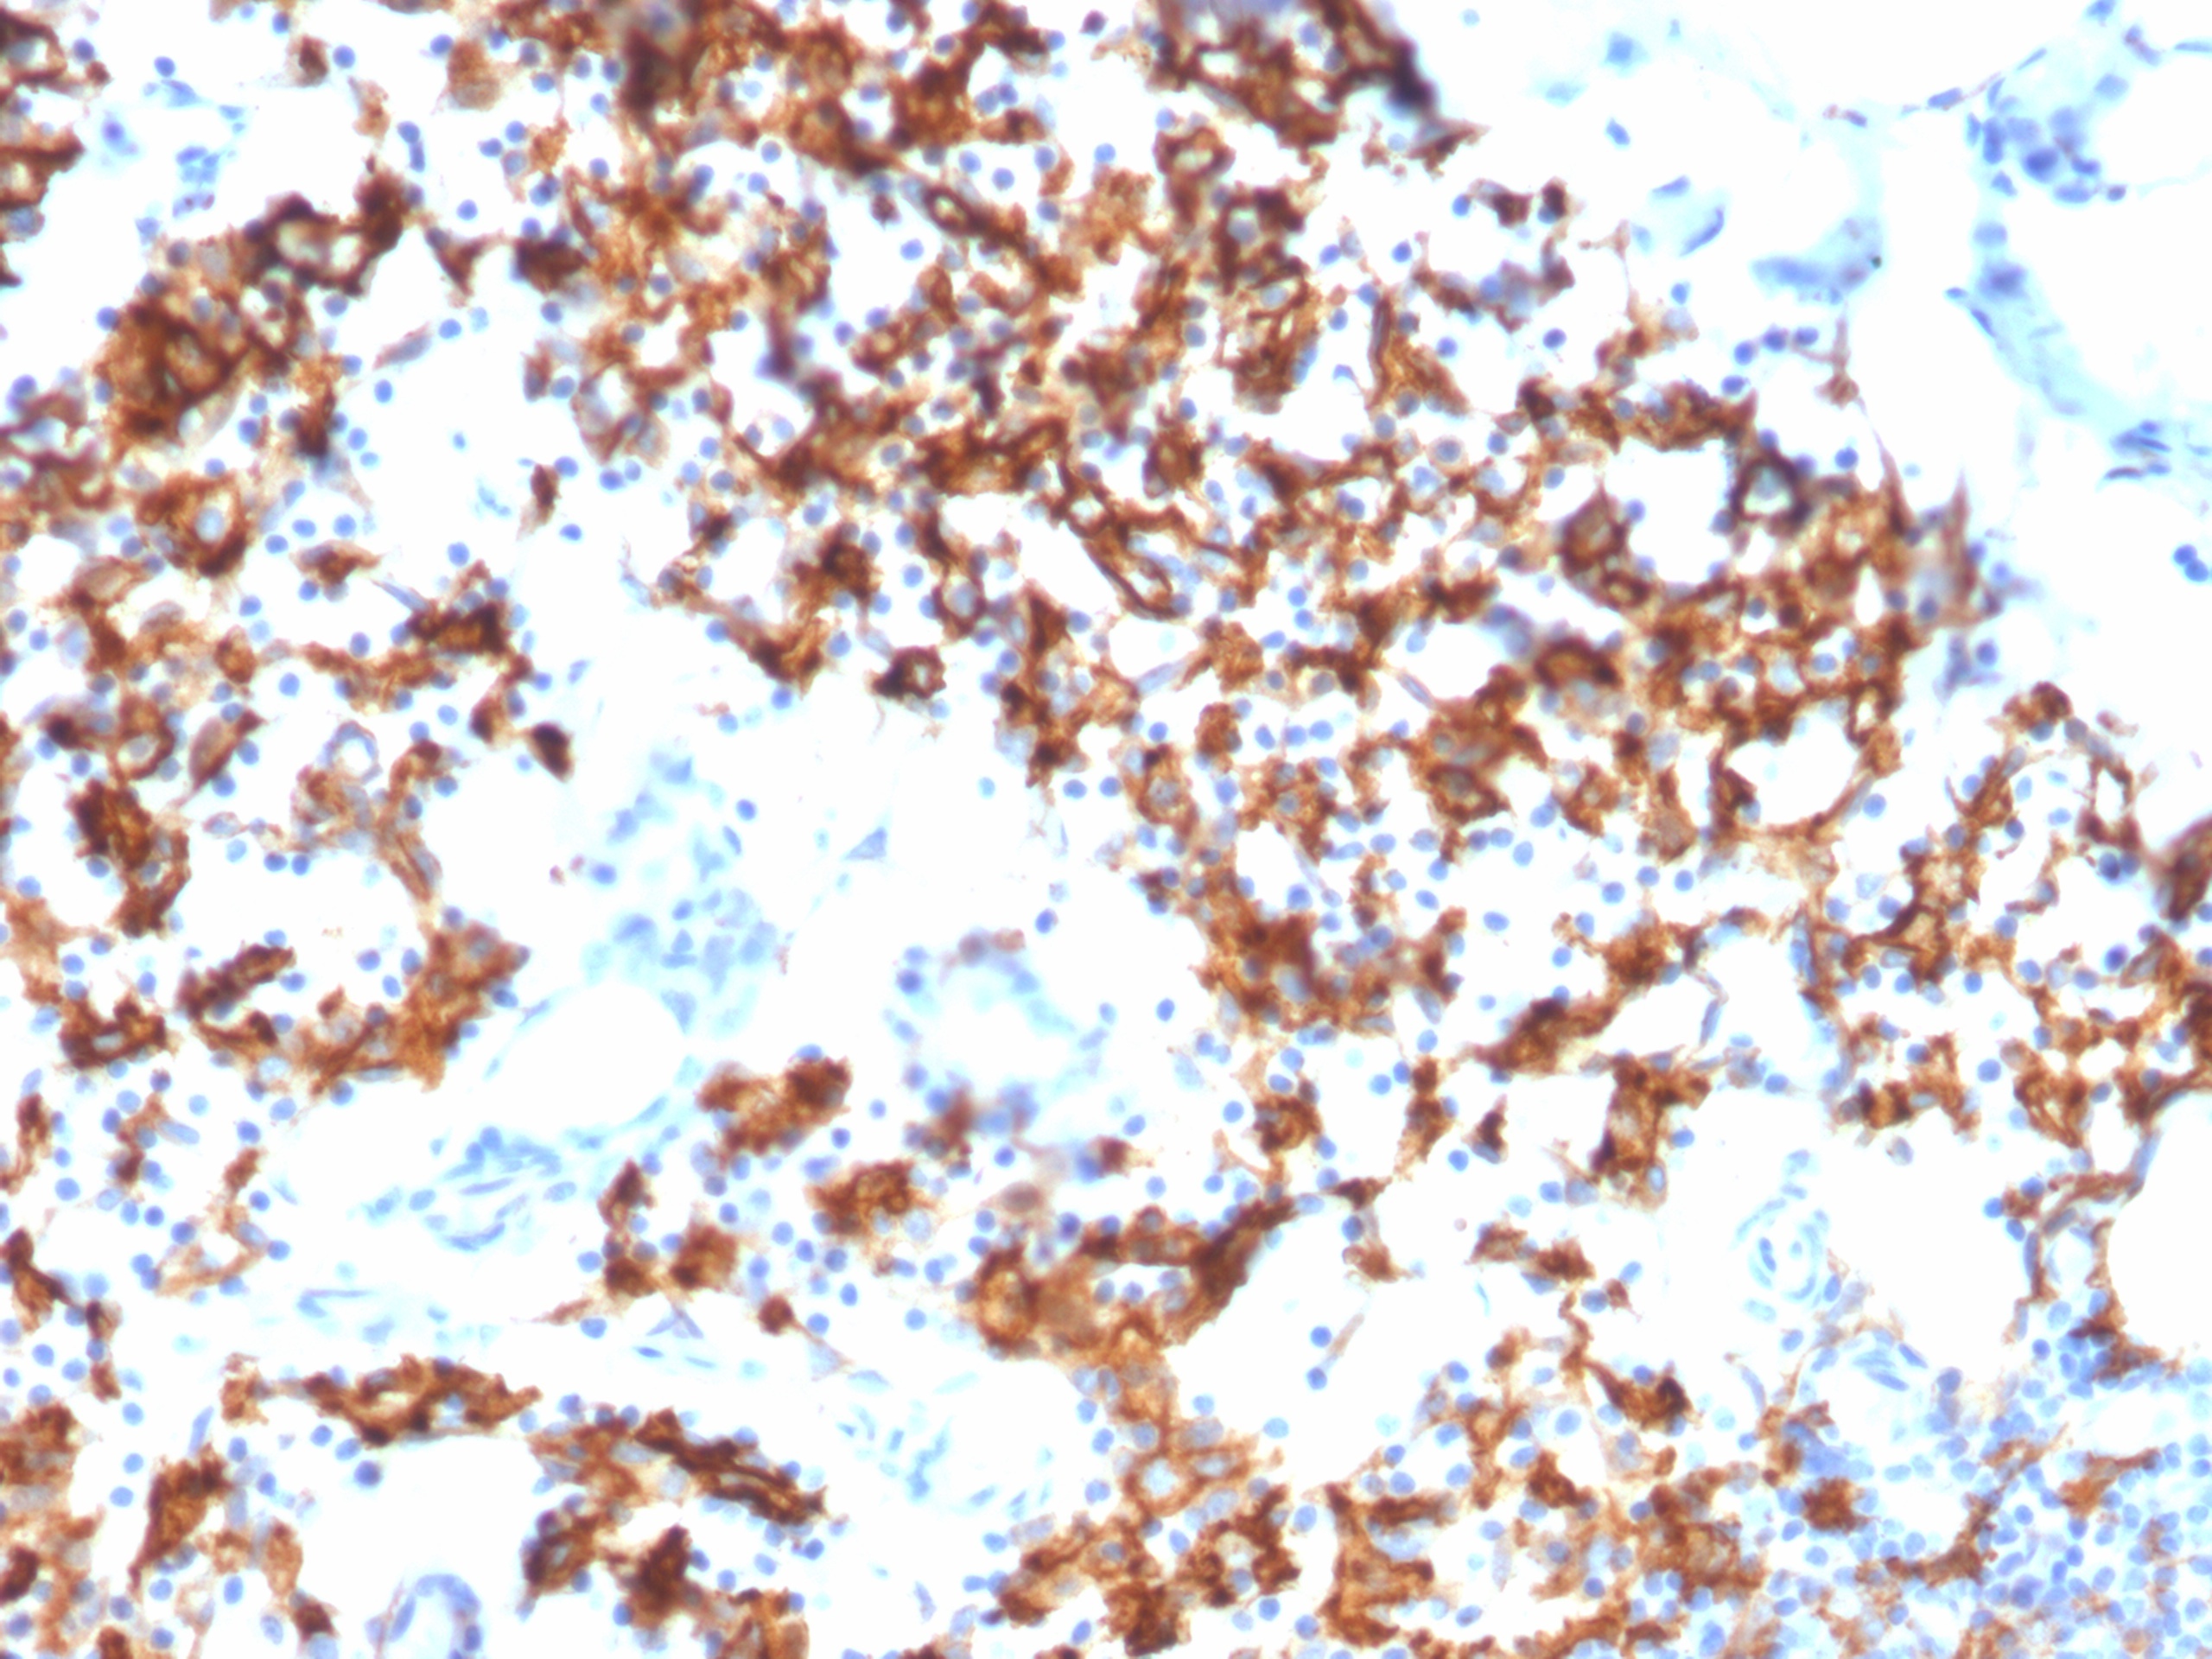
Formalin-fixed, paraffin-embedded human stomach stained with IL3RA / CD123 Mouse Monoclonal Antibody (IL3RA/1531). Inset: PBS instead of primary antibody; secondary only negative control. IL3RA Antibody in Immunohistochemistry (IHC (P))

Formalin-fixed, paraffin-embedded human lymph node stained with IL3RA / CD123 Mouse Monoclonal Antibody (IL3RA/1531). Inset: PBS instead of primary antibody; secondary only negative control.
Formalin-fixed, paraffin-embedded human stomach stained with IL3RA / CD123 Mouse Monoclonal Antibody (IL3RA/1531). Inset: PBS instead of primary antibody; secondary only negative control.

Formalin-fixed, paraffin-embedded human tonsil stained with IL3RA / CD123 Mouse Monoclonal Antibody (IL3RA/1531). Inset: PBS instead of primary antibody; secondary only negative control.

Analysis of HuProt™ Protein Array (21,000+ full-length human proteins) with IL3RA / CD123 Mouse Monoclonal Antibody (IL3RA/1531) Z-score: Signal strength (in SD above the mean) of antibody binding to each protein. S-score: Difference in Z-scores between the top target and the next best hit, indicating relative specificity. An antibody is considered specific if S ≥ 2.5. Example: Binding to protein X (Z = 43) vs protein Y (Z = 14) → S = 29.
CD123 is an interleukin 3 specific subunit of a heterodimeric cytokine receptor. The receptor is comprised of a ligand specific alpha subunit and a signal transducing beta subunit shared by the receptors for interleukin 3 (IL3), colony stimulating factor 2 (CSF2/GM-CSF), and interleukin 5 (IL5). The binding of this protein to IL3 depends on the beta subunit. The beta subunit is activated by the ligand binding, and is required for the biological activities of IL3. This gene and the gene encoding the colony stimulating factor 2 receptor alpha chain (CSF2RA) form a cytokine receptor gene cluster in a X-Y pseudo-autosomal region on chromosomes X or Y.
There are no reviews yet.